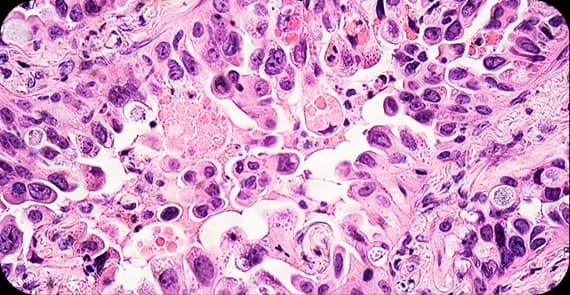
Adenocarcinoma

Beyond Conventional Treatment. Grounded in Evidence
Every year, many people in India receive a stomach cancer diagnosis. And most face that news without knowing where to turn next.
Your stomach breaks down food, absorbs nutrients, and signals your body when something is wrong. When abnormal cells grow uncontrollably in the stomach lining, they disrupt this process, often without early warning signs. That is why recognising the early symptoms of stomach cancer and seeking timely care can change outcomes.
Dr. Tarang Krishna combines clinical oncology with Cancer Healer Therapy, an integrative approach that supports your body through treatment, working with it, not against it.
The stomach is a muscular organ that digests food, absorbs key nutrients, and moves nourishment through your body. When abnormal cells grow uncontrollably in the stomach lining, they form a tumour. This is what stomach cancer is. As the disease progresses, it can affect how your body processes food, absorbs iron and vitamins, and maintains overall digestive health.
It is the most common form that originates in the mucus-producing cells of the stomach lining.
It develops in the connective tissue cells of the stomach wall. Widely known for its aggressive behaviour.
Begins in the immune cells within the stomach lining. Rare in occurrence but responds well to treatment when identified early.
It originates in the hormone-producing cells of the stomach. Slow-growing in most cases. But it requires careful monitoring for spread.
It is a particularly aggressive subtype of adenocarcinoma. Difficult to detect early and often associated with more advanced stages at diagnosis.
Stomach cancer causes are not always obvious. Many people with no apparent risk factors still develop it. Awareness is what sets early detection apart.
Biological & Genetic
Family history of stomach cancer or inherited gene mutations such as CDH1
Helicobacter pylori (H. pylori) infection
Blood Type A, which is associated with a statistically higher risk
Chronic gastritis, stomach polyps, or pernicious anaemia left unmanaged
Prior cancer treatment involving radiation to the abdominal region
Lifestyle & Environmental
Long-term consumption of smoked, salted, or processed foods
Low intake of fresh fruits and vegetables
Heavy alcohol consumption and long-term tobacco use
Obesity and poor dietary habits that contribute to chronic acid reflux
Prolonged exposure to industrial chemicals such as asbestos, coal dust, or rubber compounds
Weakened immune system due to illness or immunosuppressant medications
Early Symptoms of Stomach Cancer
Persistent indigestion or heartburn
Unexplained nausea or a feeling of fullness after eating small amounts
Blood in stool or dark, tarry stools
Mild but recurring upper abdominal pain
Unexplained rapid weight loss
Advanced Signs of Stomach Cancer
A visible lump or swelling is felt in the upper abdomen
Vomiting blood or material that resembles coffee grounds
Severe difficulty swallowing or food feeling stuck in the throat
Persistent fatigue, anaemia, or chronic loss of appetite
Yellowing of the skin or eyes indicates spread to the liver
Swollen lymph nodes felt near the collarbone or abdomen
Accurate stomach cancer diagnosis determines the right treatment. The process typically includes:
1. Blood & Stool Tests
2. Upper Endoscopy (OGD Scopy)
3. Biopsy
4. CT Scan & PET Scan
5. Endoscopic Ultrasound (EUS)
6. Staging Laparoscopy
Stomach cancer treatment generally involves one or more of the following:
1. Surgery (Gastrectomy)
2. Chemotherapy
3. Targeted Therapy
4. Immunotherapy
5. Radiation Therapy
6. Endoscopic Resection
7. Cancer Healer Therapy
Conventional treatment addresses the disease.
Cancer Healer Therapy strengthens the person undergoing it.
Developed after observing thousands of patients, this evidence-informed herbal immunotherapy works alongside your existing treatment.
Restores Natural Killer (NK) cell activity suppressed by cancer
Rebalances immune function compromised during chemotherapy
Reduces treatment-related fatigue, nausea, and immune depletion
Supports liver detoxification and cellular repair
Improves treatment tolerance and quality of life at every stage
This is not an alternative. It is an advantage.
20+ years of focused oncology experience
9 lakh+ patients supported across all stages
Team of 300+ specialists working within a unified care model
Cancer Healer Therapy was developed from clinical observation
Associated with Sri Sri Cancer Hospital, Bengaluru
Patients come when decisions feel uncertain. Clarity is what they leave with.
Indigestion, nausea, and feeling full quickly. While advanced symptoms can involve vomiting blood or unexplained weight loss. Persistent symptoms lasting more than two weeks should be evaluated by a specialist.
Stay informed with the latest in integrative cancer care, wellness tips, and program updates.